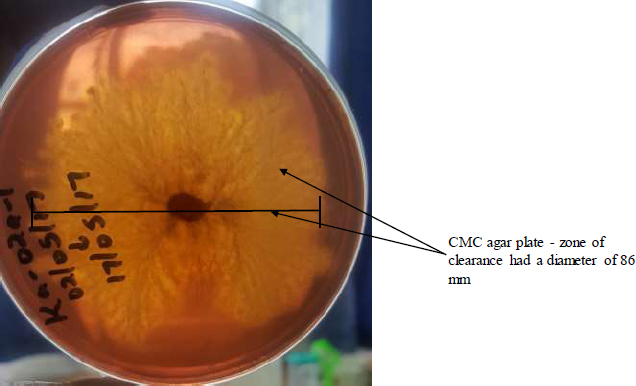

RESEARCH ARTICLEDOI: 10.2174/0118740707424062251028072626
All articles published in Open Biotechnology Journal are now available worldwide under an open-access license. No specific permission is required to reuse all or part of the Open Biotechnology Journal article, including figures and tables. Any part of an article published under a Creative Commons CC BY license may be copied without permission as long as the original material is clearly referenced.
https://openbiotechnologyjournal.com/open-access-policy.php.
Volume: 19 (2025): e18740707424062
[Electronic Publication Date: November 11, 2025]Noura B. Abdulrahman, Noor M. Ahmed and Ahmed AbdulJabbar Suleiman